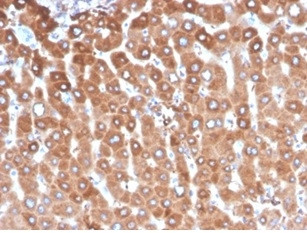
Haptoglobin (HP) Antibody in Immunohistochemistry (Paraffin) (IHC (P))

Search
NeoBiotechnologies
Haptoglobin (HP) Monoclonal Antibody (HP/3837)
{{$productOrderCtrl.translations['antibody.pdp.commerceCard.promotion.promotions']}}
{{$productOrderCtrl.translations['antibody.pdp.commerceCard.promotion.viewpromo']}}
{{$productOrderCtrl.translations['antibody.pdp.commerceCard.promotion.promocode']}}: {{promo.promoCode}} {{promo.promoTitle}} {{promo.promoDescription}}. {{$productOrderCtrl.translations['antibody.pdp.commerceCard.promotion.learnmore']}}
产品信息
3240-MSM7-P1ABX
种属反应
宿主/亚型
分类
类型
克隆号
抗原
偶联物
形式
浓度
规格
纯化类型
保存液
内含物
保存条件
运输条件
靶标信息
Haptoglobin is an a2-globulin plasma protein synthesized in the liver. It is an acute phase protein which also acts as a scavenger of hemoglobin from hemolyzed red cells. The haptoglobin monomer consists of two a and two beta chains; the a chains bay be hp1Fa, hp1Sa, or hp2a types while the beta chain is constant. Three major phenotypes are recognized: HP1-1, Hp2-1 and Hp-2-2, in which the hp1a chain bay be either the F or S type.
仅用于科研。不用于诊断过程。未经明确授权不得转售。
篇参考文献 (0)
生物信息学
蛋白别名: alpha polypeptide; beta polypeptide; binding peptide; Binding peptide (BP); Haptoglobin; Haptoglobin alpha chain / alpha(1S) beta; haptoglobin alpha(1S)-beta; Haptoglobin alpha(2FS) beta; haptoglobin alpha(2FS)-beta; haptoglobin precursor; haptoglobin, alpha polypeptide; haptoglobin, beta polypeptide; HP2 ALPHA2; HP2-ALPHA-2; HPT; MGC111141; MGC133752; preprohaptoglobin; unnamed protein product; Zonulin
基因别名: BP; HP; HP2ALPHA2; HPA1S
UniProt ID: (Human) P00738
Entrez Gene ID: (Human) 3240